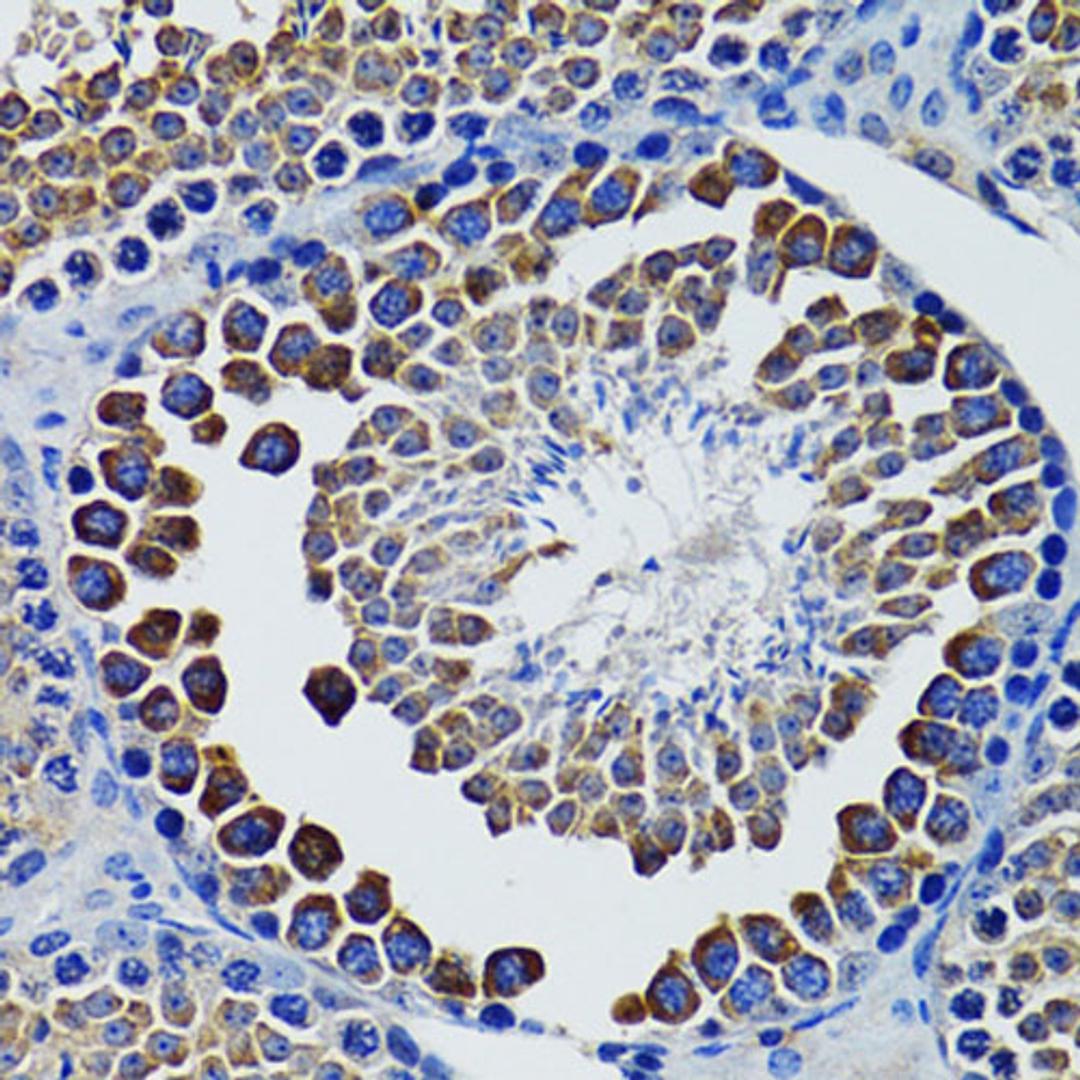
Immunohistochemistry - HEXA antibody (A12443)

HEXA Rabbit pAb
Product Details
- Cat. No.
- A12443
- Type
- Primary Antibody
- Clonality
- Polyclonal
- Host
- Rabbit

The supplier does not provide quotations for this antibody through SelectScience. You can search for similar antibodies in our Antibody Directory.
Description
This gene encodes a member of the glycosyl hydrolase 20 family of proteins. The encoded preproprotein is proteolytically processed to generate the alpha subunit of the lysosomal enzyme beta-hexosaminidase. This enzyme, together with the cofactor GM2 activator protein, catalyzes the degradation of the ganglioside GM2, and other molecules containing terminal N-acetyl hexosamines. Mutations in this gene lead to an accumulation of GM2 ganglioside in neurons, the underlying cause of neurodegenerative disorders termed the GM2 gangliosidoses, including Tay-Sachs disease (GM2-gangliosidosis type I). Alternative splicing results in multiple transcript variants, at least one of which encodes a preproprotein that is proteolytically processed.
Biological Information
- Clonality: Polyclonal
- Host: Rabbit
- Reactivity: Human, Mouse, Rat